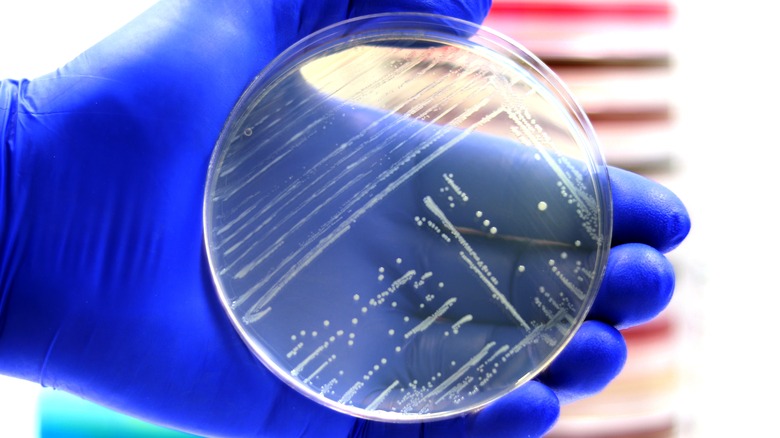

What You Need To Know About The Latest Smoked Salmon Recall
Smoked salmon is one of those foods that are deliciously decadent on the palate. Who can deny that the first smokey bite against your tongue isn't silken? Whether it's draped on a toasted bagel or crisp cracker, it compliments the rich smoothness of cream cheese, briny capers, sharp radish, and vibrant dill. Protein-packed smoked salmon also makes a killer canapé, topping crunchy thick-sliced cucumbers or deeply earthy rye toasts for an unforgettable combination. It also improves any brunch — showing up in herby omelets or creamy scrambled eggs, paired with a fizzing mimosa and juicy strawberries. Can you think of a better way to Sunday?
For now, though, your smoked salmon dreams may be on hold — unless you're willing to cook, that is. According to NBC News, Listeria monocytogenes have contaminated smoked salmon in Alabama, Colorado, Florida, Illinois, New Jersey, New York, Massachusetts, Washington State, Virginia, and Wisconsin. The recall was triggered when a routine sampling, done by the Washington State Department of Agriculture, found the bacteria in test samples. The products recalled are 4-oz. packages of St. James Smokehouse's Scotch Reserve Scottish Smoked Salmon (Product of Scotland) sold between February and June 2022 and bearing lot# 123172 and UPC code 060022710356. To date, no one has reported been ill. (via Food Safety News.)
What is Listeria and why is it in smoked salmon?
Smoked salmon is nutrient-dense, and rich in omega-3 fatty acids which boosts health, lowers inflammation and anxiety, and reduces the risk of chronic disease, according to Web MD. But, it's not for everyone. In fact, the CDC recommends that people at higher health risk (pregnant people, older adults, and those with weakened immune systems) avoid cold-smoked fish unless it's canned or has been cooked to eliminate the risk of Listeria infection.
But, what exactly is Listeria? Listeria monocytogenes are pathogenic bacteria responsible for listeriosis infection. And, an infection can cause serious problems including sepsis, meningitis, encephalitis, spontaneous abortion, fever, and gastroenteritis as researchers Denver Rogalla and Paul A. Bomar noted (via StatPearls). In fact, Listeria is the driving factor behind the no-go food list for pregnant people, temporarily eliminating raw sprouts, unpasteurized milk, soft cheeses, cold deli meats, uncooked hot dogs, and smoked seafood from their diets.
Around 260 people die and an estimated 1,600 people get listeriosis each year (via USDA). Food Safety News cautions that although Listeria-infected food may not smell off or appear spoiled, it may still be present. To limit your risk and enjoy smoked salmon, the FDA recommends following all safe food handling guidelines, and heating smoked salmon to "steaming hot," to kill any Listeria monocytogenes that may be present.